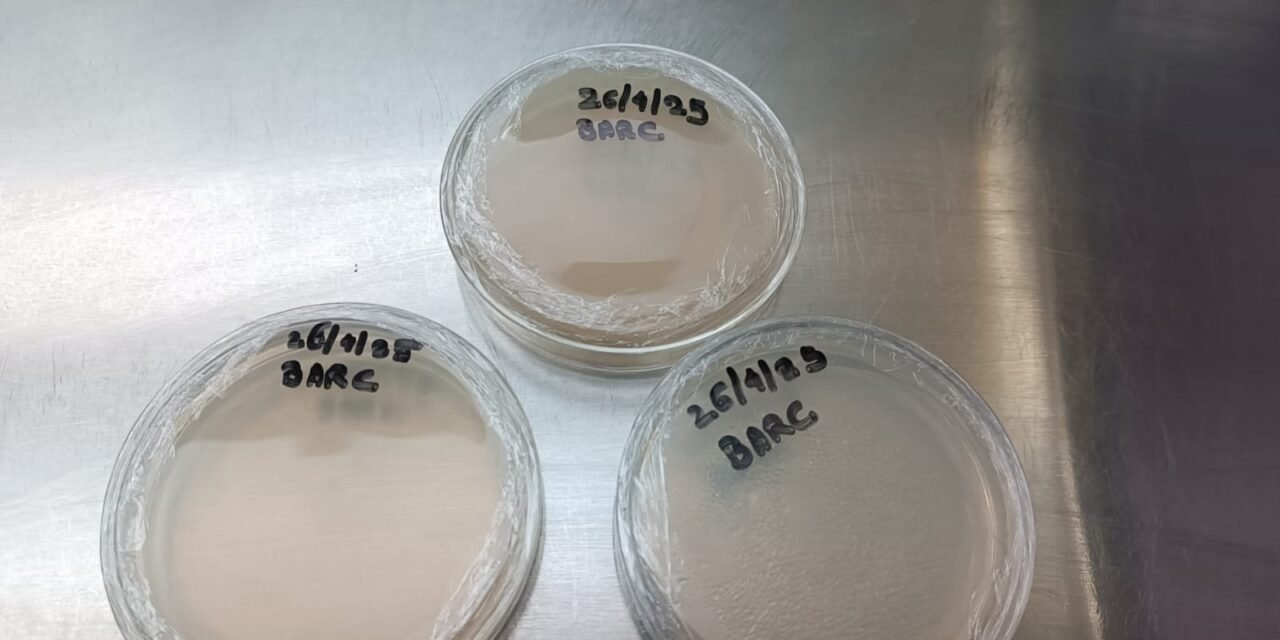
To Revive And Mass Production Of BARC Culture

AIM: To Revive And Mass Production Of BARC Culture
INTODUCTION:
Beneficial microbial consortia (BARC) are carefully selected combinations of multiple microorganisms like bacteria, fungi, and actinomycetes that work synergistically to enhance organic farming, soil health, composting, and bioremediation. In organic farming, they promote plant growth by fixing nitrogen, solubilizing phosphate, mobilizing potassium, producing phytohormones, and suppressing diseases through beneficial microbes.
REQUIREMENT:
For Plating of BARC culture: Available BARC Culture, PDA and NA Media ,Petri plates,Spreader,Microtips and micropipette,Autoclave,Incubator Laminar, Beaker.
26/4/25
For Plating of BARC culture
Prepared PDA and NA media .
Autoclave media, petri plates, distilled water, test tubes,spreader,microtips at 121C temp and 15 psi pressure for 20 min.
For Maintaining ascetic condition : At the same time, clean LAF(laminar air flow) using acetone / 80% ethanol and ON UV light for 15-20 min. After 20 min OFF UV light and and ON blower and day light.
Then all remaining procedure carried out under ascetic conditions. After sterilization, media poured into petri plates
After solidification of media, add 0.2 ml of aliquot of BARC from test tube on petri plate. And spread equally on whole petri plate.
Follow same protocol for all the petri plates with same concentration of BARC culture and spread equally by using spreader.
Packed petri plates with parafilm. And kept it in incubator at 37 C temp for 3/4 days.
Keep petri plate in incubator for microorganisms growth

29/4/25
Preparation and Inoculation in Nutrient Broth media:


Prepare 500 ml NB broth and sterilized by using autoclave at 121° C temp and 15 lbps pressure for 20 min.
In aseptic condition after the complete cooling of NB broth, microbial colonies from incubated plates are suspended into the broth with the help of wire loop or saline suspension.
After suspension this broth is kept on orbital shaker for multiplication of bacteria at 125 rpm for 4-5 days.
Keep the NB on orbital shaker for microorganisms growth.
3/5/25
Observation And Result:
BARC culture showed vigorous growth in NB broth, with maximum turbidity by Day 4-5, indicating a peak in biomass.
Mass multiplication of BARC culture has been successfully accomplished.